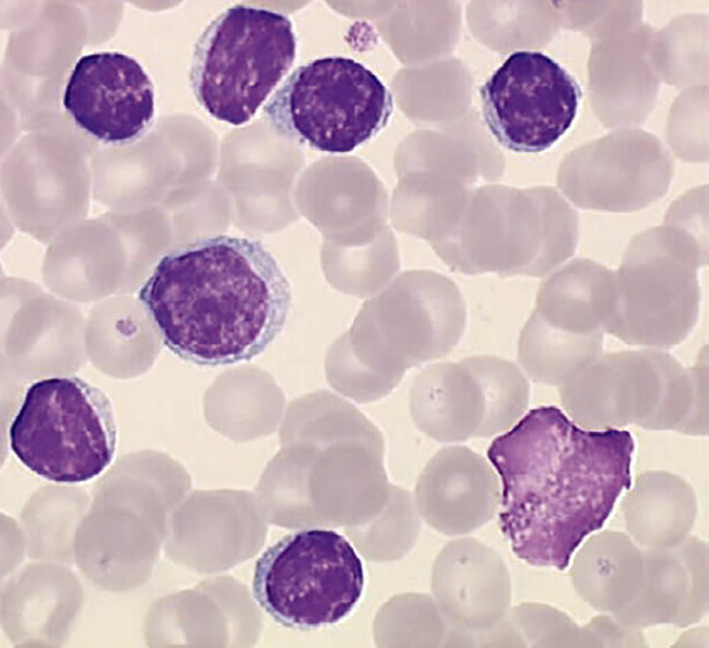

Épidémiologie
On note une plus grande incidence de la maladie chez les Caucasiens, très faible en Asie. Le risque est supérieur en cas d’histoire familiale, celui de second cancer au cours de la maladie est plus élevé (poumon, peau et carcinome de Merkel).
Diagnostic et première évaluation
Le diagnostic est affirmé par la mise en évidence d’une population mono- typique (expression d’une seule chaîne légère) de lymphocytes B CD19+ et CD5+. Un score immunophénotypique, dit de « Matutes », ≥ 4 confirme la LLC. Ainsi pas besoin d’analyse médullaire ni de biopsie ganglionnaire.
Un clone < 5 × 109/L et un score Royal Marsden Hospital (RMH) > 3 en l’absence d’adénopathie ou de cytopénie est une lymphocytose B monoclonale (qui peut évoluer vers une LLC, 1 %/an/patient).
Il est important d’identifier une histoire familiale d’hémopathie ou personnelle de maladie auto-immune et d’infections à répétition. L’examen physique recherche des signes généraux, des adénopathies périphériques, une hépato- ou splénomégalie, une hypertrophie amygdalienne.
Sont indispensables : NFS avec réticulocytes, électrophorèse des protides, test de Coombs, LDH et bêta-2-microglobuline.
Aucune imagerie n’est nécessaire en l’absence d’indication thérapeutique, pas plus que l’identification des facteurs pronostiques, mais le temps de doublement des lymphocytes, l’expression du CD38 et les taux de LDH et bêta-2-microglobuline sont des marqueurs de prolifération simples à obtenir. Les malades peuvent ensuite être catégorisés selon la classification de Binet (
Qui traiter ?
Une anémie stable au stade A doit être explorée (y a-t-il insuffisance médullaire, une hémolyse, une cause non liée à la LLC telle la carence martiale ?), avant de conclure à son lien avec la maladie.
Les critères de progression sont les suivants :
– insuffisance médullaire avec anémie et/ou thrombopénie allant en s’aggravant. Le caractère progressif de ces anomalies est important ;
– splénomégalie massive ou évolutive ou symptomatique ;
– adénopathies symptomatiques ou progressives ou cliniquement significatives ;
– lymphocytose croissante (temps de doublement inférieur à 6 mois) ;
– anémie hémolytique auto-immune ou thrombopénie auto-immune ne répondant pas aux traitements standard ;
– au moins un des signes suivants : fatigue significative, perte de poids non intentionnelle de plus de 10 % dans les 6 mois, fièvre supérieure à 38 °C depuis 2 semaines ou plus sans signe d’infection, sueurs nocturnes depuis plus d’un mois.
En cas d’abstention thérapeutique, une évaluation clinique et biologique est recommandée tous les 6-12 mois sans imagerie systématique.
Prévenir le risque infectieux : un enjeu majeur
– la vaccination antigrippale annuelle ;
– celle contre le pneumocoque (Prevenar 13, suivi 8 semaines plus tard de Pneumovax). Un rappel du 23-valent 5 ans plus tard est proposé ;
– celle contre Haemophilus influenzae : Act-Hib 1.
Les vaccins vivants atténués sont contre-indiqués, mais le rapport bénéfice-risque doit être évalué au cas par cas.
Les patients atteints de LLC ont une susceptibilité particulière aux infections bactériennes au niveau respiratoire, urinaire et cutané. Les germes les plus fréquents sont : Streptococcus pneumoniae, Haemophilus influenzae, Staphylococcus aureus, Streptococcus pyogenes, et Escherichia coli.
Une antibioprophylaxie est utilisée dans certains pays : azithromycine (250 mg × 3/semaine) en cas de bronchectasie, en continu.
Les traitements spécifiques de la LLC peuvent favoriser certaines infections (
La supplémentation en immunoglobulines polyvalentes est à réserver aux patients ayant une hypogammaglobulinémie profonde (< 4 g/L) et victimes d’infections répétées avec hospitalisation.
Évaluation préthérapeutique
Cytogénétique. Le caryotype est recommandé mais non obligatoire ; complexe (associant plusieurs anomalies), il a une valeur pronostique défavorable. L’analyse en FISH doit être réalisée afin d’identifier les mutations suivantes del17p, del11q, del13q et la trisomie 12.
Biologie moléculaire. Des mutations de la chaîne lourde des immunoglobulines (IgVH) doivent être recherchées car le pronostic des patients au statut « non muté » est plus défavorable que celui des sujets « mutés ». Par ailleurs, les nouveaux traitements ciblés sont particulièrement intéressants en l’absence de mutation.
Il est indispensable de rechercher des mutations de TP53, qui interdisent l’immunochimiothérapie. La technique de choix est le NGS (pour Next Generation Sequencing).
Traitements de première ligne
En l’absence d’anomalie de TP53, on détermine l’éligibilité à un traitement contenant de la fludarabine (Fludara et génériques) défini comme un âge < 65- 70 ans, l’absence de comorbidité significative et une fonction rénale adaptée (clairance > 60 mL/min). Le statut mutationnel IgVH doit ensuite être défini.
Sujets éligibles à la fludarabine. Chez les patients mutés IgVH, un traitement par fludarabine + cyclophosphamide (Endoxan) + rituximab (MabThera, Rixathon, anticorps monoclonal) doit être privilégié.
Si le patient est non muté, on préfère l’ibrutinib (Imbruvica, inhibiteur de tyrosine kinase, médicament ciblé administré par voie orale) +/- obinutuzumab (Gazyvaro, anticorps monoclonal proche du rituximab).
Non éligibles à la fludarabine. Les patients mutés peuvent recevoir soit une immunochimiothérapie moins intense (rituximab associé à la bendamustine – Levact et générique – ou chloraminophène – Chlorambucil – avec un autre anticorps, l’obinutuzumab), soit l’ibrutinib +/- rituximab.
Non mutés, la priorité est donnée à l’ibrutinib +/- obinutuzumab, plus rarement : immunochimiothérapie atténuée.
Une anomalie de TP53 fait prescrire ibrutinib +/- obinutuzumab ou vénétoclax (Venclyxto, médicament ciblé, anti-bcl-2).
Traitement de la rechute
Après immunochimiothérapie. Le choix standard est l’ibrutinib, mais l’association vénétoclax-rituximab peut également être tentée. Il n’y a plus de place pour l’immunochimiothérapie.
Après ibrutinib. Il est important de distinguer ceux progressant sous traitement, et chez qui on recherche des mutations de résistance, et ceux intolérants au médicament.
Dans le premier cas, le vénétoclax est à privilégier, seul ou en combinaison avec le rituximab. Dans le second, la reprise du traitement doit être envisagée au cas par cas en fonction de la nature et du caractère réversible de la toxicité. Si la reprise est impossible, les patients sont traités par vénétoclax ou rituximab-vénétoclax.
1. Cytopénies auto-immunes : physiopathologie complexe
Complications fréquentes de la LLC, elles touchent de 4 à 14 % des patients à n’importe quel moment de la maladie. L’anémie hémolytique auto-immune et le purpura thrombopénique immunologique (PTI) sont en général traités par corticostéroïdes à une dose initiale de 1-2 mg/kg/j ; les taux de réponse sont d’environ 70 %, mais ces réponses sont rarement durables. Les immunoglobulines intraveineuses (IgIV) ne sont administrées qu’en contexte d’urgence, et les analogues de la thrombopoïétine (Nplate, Revolade) sont parfois utiles. En l’absence de progression concomitante de la maladie, les immunosuppresseurs tels la ciclosporine peuvent être prescrits. En cas de progression, celle-ci doit être traitée en tant que telle pour espérer un contrôle du processus auto-immun.
2. Syndrome de Richter : une évolution très péjorative
Transformation en lymphome aggressif, il est suspecté devant des signes généraux (fatigue, sueurs nocturnes, fièvre, perte de poids), l’apparition rapide d’une adénopathie asymétrique, une localisation extraganglionnaire, une hypercalcémie et des LDH élevés.
On demande alors une TEP TDM qui guidera la biopsie, indispensable au diagnostic.
Il s’agit dans 90 % des cas d’un lymphome B diffus à grande cellules, dont le diagnostic peut être complexe et dans 10 % des cas d’une maladie de Hodgkin. Le pronostic est très réservé, et les chimiothérapies temporairement efficaces.
Sud A, Chattopadhyay S, Thomsen H, et al. Analysis of 153 115 patients with hematological malignancies refines the spectrum of familial risk. Blood 2019;134:960-9.
Rubin LG, Levin MJ, Ljungman P, et al. 2013 IDSA clinical practice guideline for vaccination of the immunocompromised host. Clin Infect Dis 2014;58:309-18.
Andersen MA, Moser CE, Lundgren J, Niemann CU. Epidemiology of bloodstream infections in patients with chronic lymphocytic leukemia: a longitudinal nation-wide cohort study. Leukemia 2019;33:662-70.
Mulligan SP, Shumack S, Guminski A. Chronic lymphocytic leukemia, skin and other second cancers. Leuk Lymphoma 2019;60:3104-6.
Hallek M. Chronic lymphocytic leukemia: 2020 update on diagnosis, risk stratification and treatment. Am J Hematol 2019;94:1266-87.
Parikh SA, Kay NE, Shanafelt TD. How we treat Richter syndrome. Blood 2014;123:1647-57.